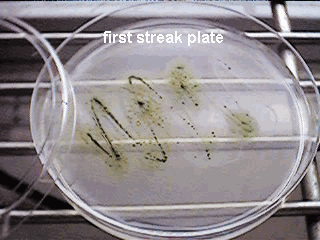
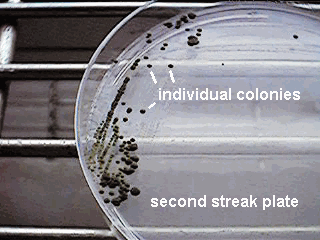

Paso 6: Toma de muestras del medio de las algas

Retire la tapa del tarro de masón y con cuentagotas de la inmersión en el medio de las algas y obtener una muestra. Colocar la tapa en el tarro de masón y abrir caja Petri #1. Colocar una gota del medio de las algas en la placa y utilizar el tubo de muestra para hacer una forma de Z la mayoría de la forma en el agar pero no hasta el borde.
Cierre la caja Petri y repita este proceso para cada toma de muestra. Cuando esté hecho retirar el tubo de muestra y el masón de la jarra de la incubadora. Esperemos que hayas colocado la incubadora en un lugar donde la luz está disponible (en el interior cerca de una ventana?) y la bombilla suple el calor. Usar una potencia más baja para suministro constante ya que el calor se acumulan en la incubadora con el tiempo. Se trata de algas bien como se caliente.
Después de 5 o 6 días las células habrá crecido en bastante a las colonias de forma. Estas colonias en esta primera placa racha a menudo tienden a crecer juntos, así que es difícil escoger de colonias con una única especie. Que tenga que raspar algunas colonias de la primera placa y raya nuevamente en una segunda placa para conseguir buena separación.
Bueno ahora vamos a las colonias individuales para producir cultivos de las especies individuales.